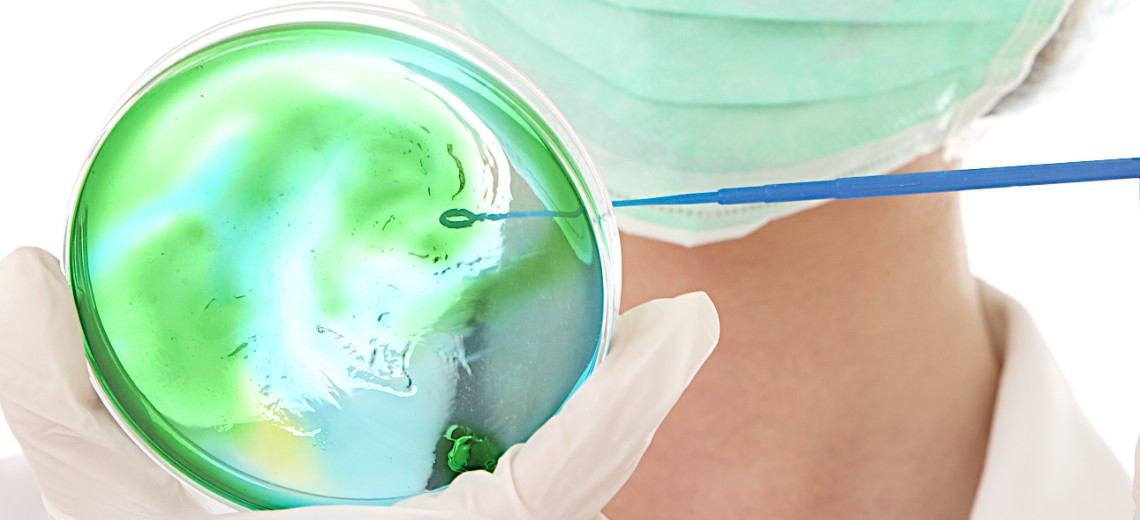
Cáncer de Cuello Uterino
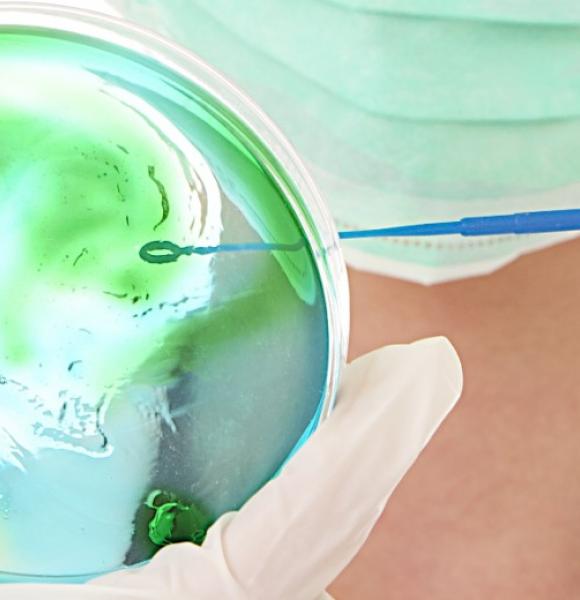
Cáncer de Cuello Uterino  mobile

Programa dirigido a todas las mujeres entre 25 y 69 años o las menores de 25 años con vida sexual activa; no se genera cobro de cuota moderadora, es de acceso libre.
En Colombia, el cáncer de cuello uterino es de alta incidencia y mortalidad, por eso contamos con un programa de prevención y control de esta enfermedad.
La detección temprana del cáncer de cuello uterino corresponde al conjunto de actividades, intervenciones y procedimientos dirigidos a las mujeres entre 25 y 69 años o menores de 25 años con vida sexual activa, para la toma de citología cervicouterina.
La atención de lesiones preneoplásicas de cuello uterino corresponde al conjunto de actividades, intervenciones y procedimientos dirigidos a las mujeres con diagnóstico de lesión preneoplásica, tendientes a incrementar las posibilidades de curación, minimizar los riesgos de complicación y aumentar el tiempo de sobrevida y su calidad.
Cada año para control y según indicación del profesional médico.